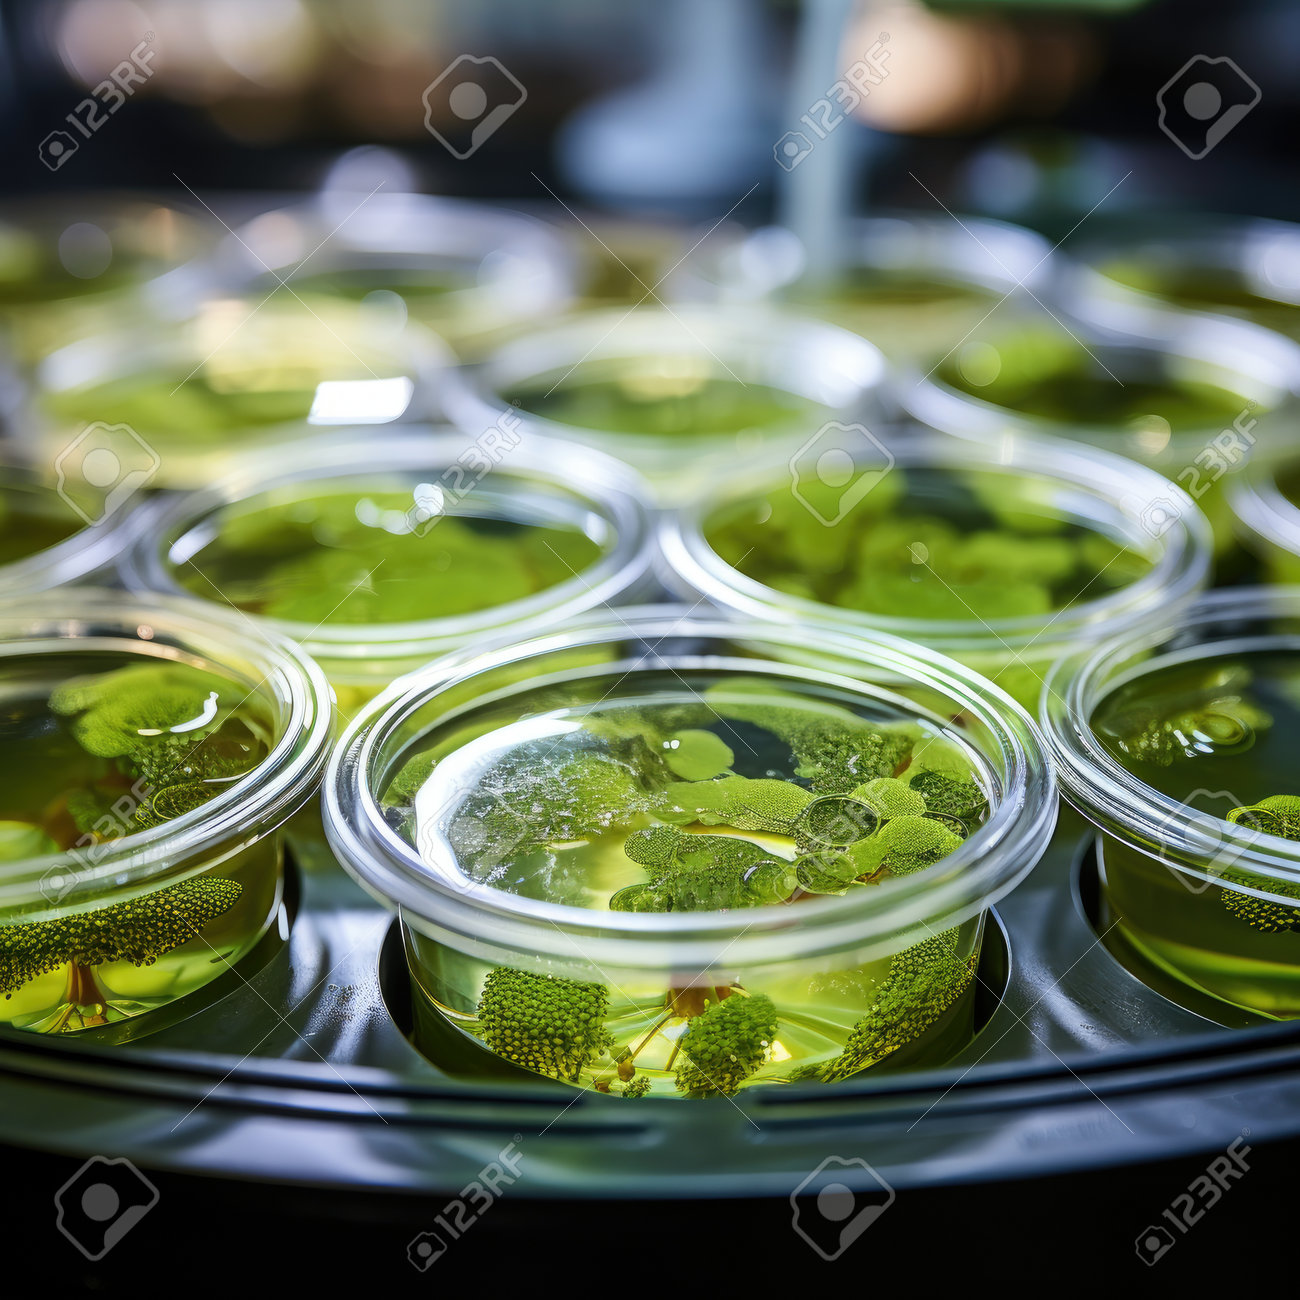
etiam-dictum-ipsum-a-felis

Download
Close
Автор:
id:
Ключевые слова:
biochemistry, biology, biotechnology, experiment, glass, health, healthcare, lab, laboratory, medical, medicine, microbiology, microscope, pharmaceutical, pharmacy, research, science, scientific, scientist, test,





